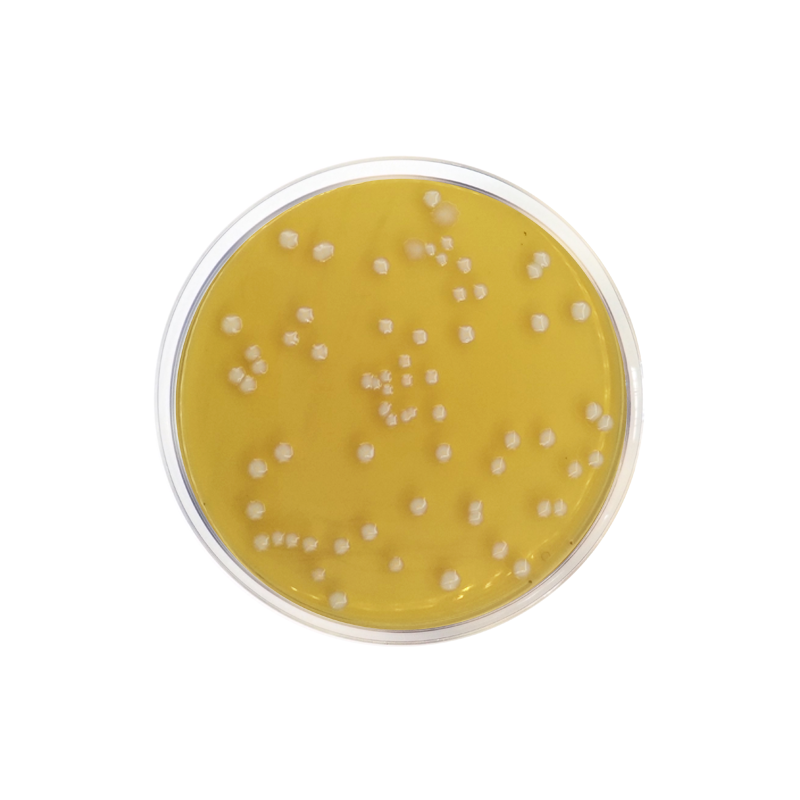
Raka Ray Agar 500g

Description
Synonym(s): Lactic Acid Bacteria Selective Agar Base
General description
Raka-Ray Agar was formulated by Saha, Sondag and Middlekauff to monitor the brewing process and analyze it for a wide range of bacteria. The media is found to be superior to several other media for the cultivation of Lactobacilli and Pediococci. It also suppresses the growth of non-lactic acid facultative bacteria that are often associated with lactic beer spoilage.
Application
Raka-Ray Agar is recommended for selective isolation of lactic acid bacteria encountered in beer and the brewing process.
Preparation Note
Suspend 38.5 g in 500 ml of distilled water.
Bring to the boil and dissolve the medium completely.
Distribute into tubes or bottles and sterilize by autoclaving at 121°C for 15 minutes. Cool to 50-55°C and add contents of 1vial of lactic acid bacteria selective supplement. Add 3.5 ml of Cycloheximide solution.
Mix well and pour into sterile petri dishes or dispense as desired.
PROPERTIES
sterility
non-sterile
form
powder
shelf life
limited shelf life, expiry date on the label
composition
N-acetyl glucosamine, 0.5 g/L
agar, 17.0 g/L
betaine hydrochloride, 2.0 g/L
casein enzymic hydrolysate, 20.0 g/L
diammonium hydrogen-citrate, 2.0 g/L
fructose, 5.0 g/L
glucose, 5.0 g/L
liver concentrate, 1.0 g/L
magnesium sulphate, 2.0 g/L
maltose, 10.0 g/L
manganese sulfate, 0.66 g/L
monopotassium phosphate, 2.0 g/L
potassium aspartate, 2.5 g/L
potassium glutamate, 2.5 g/L
yeast extract, 5.0 g/L
manufacturer/tradename
NutriSelect® Plus
final pH
5.4±0.2 (25 °C)
application(s)
agriculture
bioburden testing
food and beverages
microbiology
suitability
Pediococcus spp.
selective for Lactobacillus spp

Reviews
There are no reviews yet.